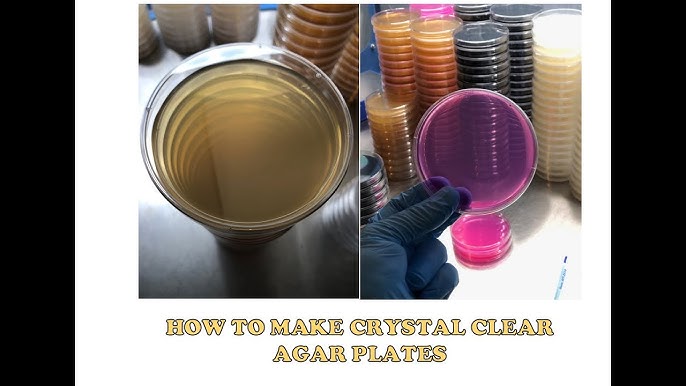

12+ Mushroom Agar Recipe

Organic Blue Oyster Mushroom Grain Spawn North Spore


Lqvt31iu1h7eem

How To Make Sterilized Agar Plates Freshcap Mushrooms

How To Make Agar Plates Youtube

Mh Food All Purpose Mushroom Seasoning 150g Vegan District Malaysia

Shroom Academy Agar Preparation For Mushroom Cultivation Youtube

The Official Psilocybe Natalensis Thread Mushroom Cultivation Shroomery Message Board

Cracked The Code With Agar Recipe R Shroomers

The Best Marinated Honey Mushrooms Forager Chef

How To Work With Mushroom Cultures On Agar Naturemade Mushrooms

Recipe Light Malt Extract Agar Lmea Mycology Start

The Official Psilocybe Natalensis Thread Mushroom Cultivation Shroomery Message Board

List Of Agar Recipes For Mushroom Cultivation

How To Use Agar In Mushroom Cultivation Doubleblind Mag

List Of Agar Recipes For Mushroom Cultivation

How To Make Sterilized Agar Plates Freshcap Mushrooms

Recipe Light Malt Extract Agar Lmea Mycology Start
How To Make Agar Plates Youtube